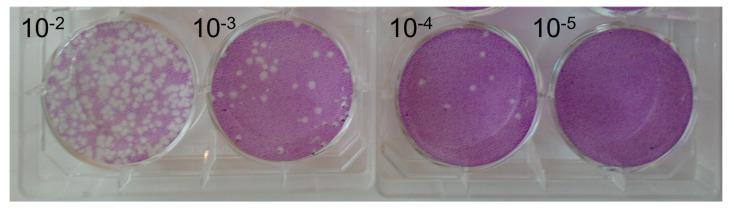
https://cdn.ncbi.nlm.nih.gov/pmc/blobs/fbe1/10459264/4430857df442/pathogens-12-01022-g002.jpg

温度对非洲猪瘟病毒BA71V毒株在环境水样中稳定性的影响
The Effect of Temperature on the Stability of African Swine Fever Virus BA71V Isolate in Environmental Water Samples.
作者信息
Loundras Eleni-Anna, Netherton Christopher L, Flannery John, Bowes Michael J, Dixon Linda, Batten Carrie
机构信息
The Pirbright Institute, Ash Road, Pirbright, Woking GU24 0NF, UK.
Department of Animal Health, Technological University of the Shannon, Athlone Campus, N37HD68 Athlone, Ireland.
出版信息
Pathogens. 2023 Aug 8;12(8):1022. doi: 10.3390/pathogens12081022.
African swine fever virus (ASFV) is known to be very stable and can remain infectious over long periods of time especially at low temperatures and within different matrices, particularly those containing animal-derived organic material. However, there are some gaps in our knowledge pertaining to the survivability and infectivity of ASFV in groundwater. This study aims to determine the stability and infectivity of the cell culture-adapted ASFV strain BA71V by plaque assay after incubation of the virus within river water samples at three different environmentally relevant temperatures (4 °C, 15 °C, and 21 °C) over the course of 42 days. The results from this study indicate that ASFV can remain stable and infectious when maintained at 4 °C in river water for more than 42 days, but as incubation temperatures are increased, the stability is reduced, and the virus is no longer able to form plaques after 28 days and 14 days, respectively, when stored at 15 °C and 21 °C. Characterizing the survivability of ASFV in groundwater can allow us to develop more appropriate inactivation and disinfection methods to support disease control and mitigate ASFV outbreaks.
已知非洲猪瘟病毒(ASFV)非常稳定,尤其在低温以及不同基质中,特别是含有动物源有机物质的基质中,能长时间保持传染性。然而,我们对ASFV在地下水中的生存能力和传染性的了解存在一些空白。本研究旨在通过蚀斑试验,确定在三种与环境相关的不同温度(4°C、15°C和21°C)下,将细胞培养适应的ASFV毒株BA71V在河水样本中孵育42天后的稳定性和传染性。本研究结果表明,ASFV在河水中于4°C下保持42天以上仍可保持稳定和传染性,但随着孵育温度升高,稳定性降低,分别在15°C和21°C下储存时,病毒在28天和14天后不再能够形成蚀斑。了解ASFV在地下水中的生存能力可以使我们开发出更合适的灭活和消毒方法,以支持疾病控制并减轻ASFV疫情。